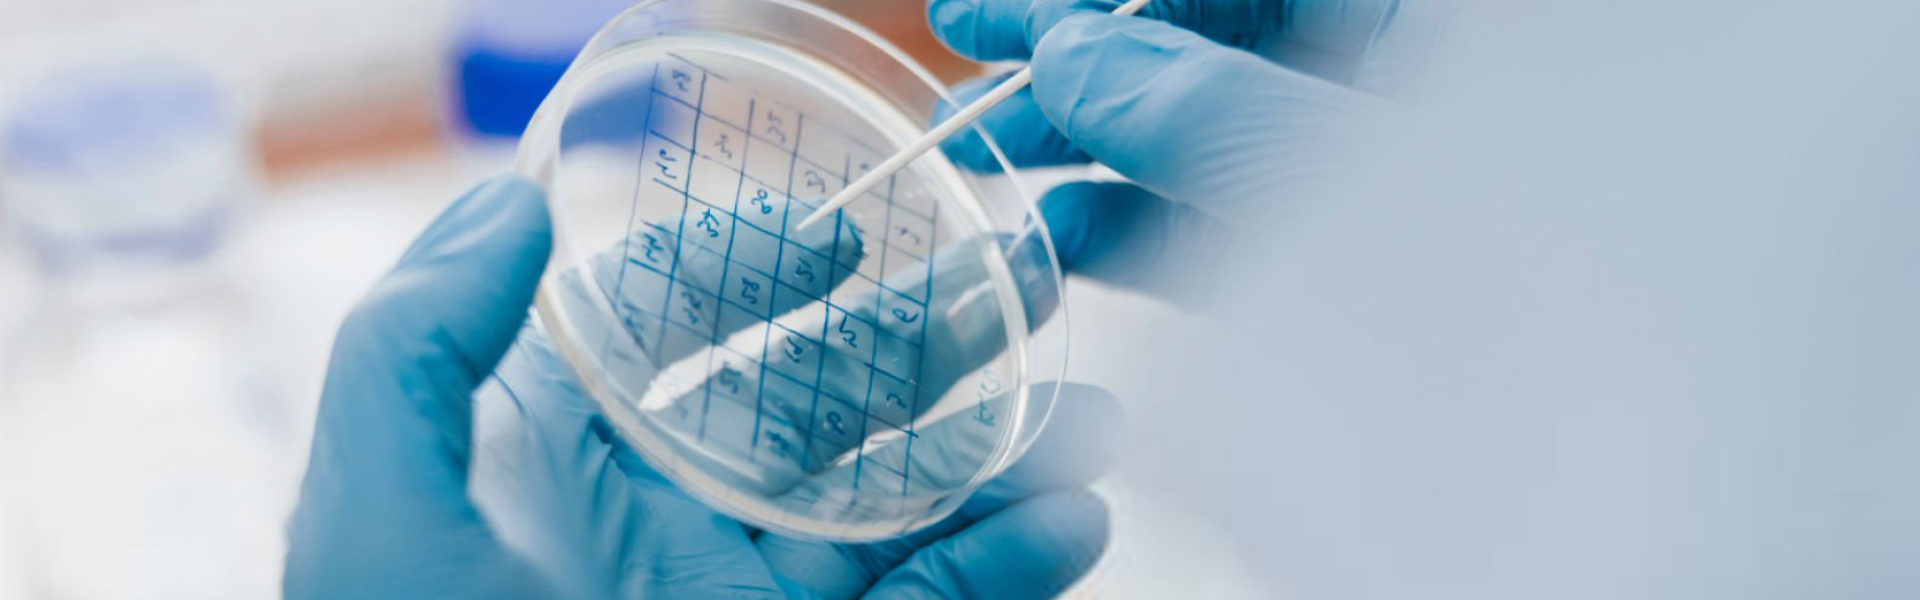
Research Enterprise

Research
We are home to new discoveries and scientific breakthroughs, illuminating the fringes of human understanding.
19th
Worldwide in Times Higher Education (THE)'s Impact Rankings 2025
(No. 1 in Hong Kong)
21%
of Faculty Members were recognized as the world's Top 2% scientists
Stanford University 2025
#6
QS Asia University Rankings 2026
(No. 2 in Hong Kong)
With Research and Discovery Champions Award
Research Highlights & Achievement
Our talented researchers are tirelessly breaking new ground and addressing the world’s most complex challenges.
Our researchers chart the cutting-edge of innovation, pushing the boundaries of knowledge and making breakthroughs that benefit humanity. Explore our achievements and witness the transformative power of discovery.

Research News
Research Enterprise
Our students and researchers are supported by a backbone of communal state-of-the-art central research facilities, institutes, centers, and labs. These central platforms create a synergistic environment fostering interdisciplinary collaboration and learning.
National Labs & Centers
We partner with State Key Laboratory and the Hong Kong Branch of the Chinese National Engineering Research Center, providing top-level laboratory facilities.
Research Institutes
Tackling thematic and cutting-edge research priorities, HKUST’s research institutes pool interdisciplinary expertise, share knowledge and foster young talent.
Research Centers
Our research centers foster collaboration and interdisciplinary research in their respective fields.
Joint Research Units
We partner with leading institutions, providing collaborative platforms for knowledge advancement.
Support & Opportunities for Researchers
Take your research further with our support and opportunities.
Research Opportunities Programs


Immerse yourself in a variety of tailor-made research projects with world-renowned researchers.

Research Collaboration
We are committed to enhancing our collaborative culture to create far greater impact than can be achieved by individuals alone.

International Partners
HKUST collaborates with leading overseas institutions, complementing our strengths and academic priorities.
Chinese Mainland Engagement
HKUST maintains impactful, long-term collaborations with leading Chinese Mainland institutions across the Greater Bay Area including Hong Kong, Guangzhou, Shenzhen and Foshan.
Industry Partnerships
HKUST collaborates with prestigious institutions and corporations to drive technological innovation, translating cutting-edge research into practical solutions.














































